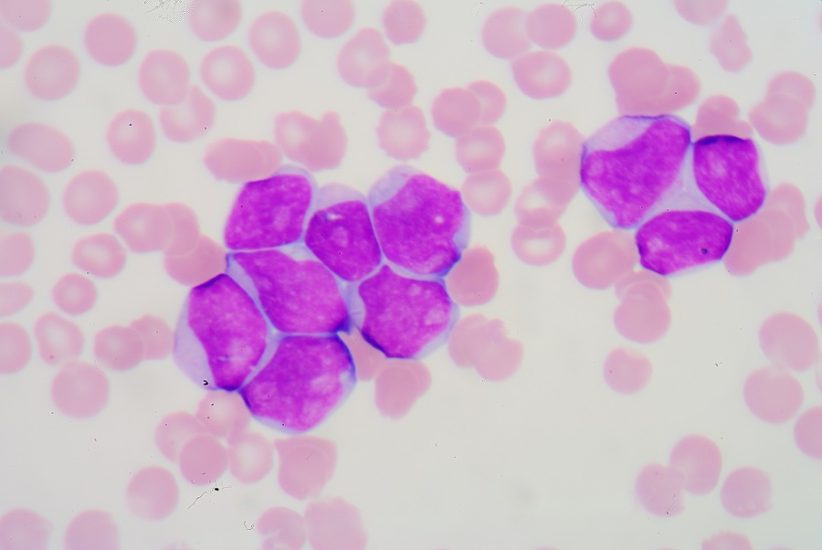

Doug Olson ndjehej i lodhur në vitin 1996 kur shkoi te një mjek për t’u ekzaminuar. Por nga lodhja analizat rezultuan se ai kishte leucemi limfocitare kronike, një kancer gjaku që godet kryesisht njerëzit e moshuar dhe përbën rreth një të katërtën e rasteve të reja të leukemisë. Ai bëri katër raunde kimioterapie, por kanceri vazhdoi të kthehej. Onkologu i tij, David Porter në Universitetin e Pensilvanisë, i ofroi atij një shans për të qenë ndër pacientët e parë që provonin diçka të pa zakontë, të njohur si terapia e qelizave “T CAR”.
Në vitin 2010, ai u bë i dyti nga tre pacientët që morën trajtimin e ri. Në atë kohë, ideja për këtë lloj terapie nuk mendohej tha Carl June, autori kryesor.
“Ne menduam se ata do të largoheshin brenda një ose dy muajsh,” tha June.
Tani, një dekadë më vonë, ai raporton se pritjet e tij ishin krejtësisht ndryshe. Në një studim të botuar të mërkurën në revistën “Nature” June dhe kolegët e tij Joseph Melenhorst dhe Porter, raportojnë se trajtimi “CAR T” bëri që kanceri të zhdukej në dy nga tre pacientë në atë provë të hershme. Të gjithë kishin leuçemi limfocitare kronike. Befasia e madhe ishte se edhe pse kanceri dukej se ishte zhdukur prej kohësh, qelizat “CAR T” mbetën në qarkullimin e gjakut të pacientëve, duke qarkulluar si “roje”.
“Tani më në fund mund të themi fjalën shërim me qelizat CAR T,” tha June.
Sipas ekspertëve rezultatet japin shpresë se kanceri i tyre do të mposhtet. Por misteret mbeten. Trajtimi përfshin heqjen e qelizave T, qelizave të bardha të gjakut që luftojnë viruset, nga gjaku i një pacienti dhe inxhinierinë gjenetike të tyre për të luftuar kancerin. Pastaj qelizat e modifikuara futen përsëri në gjakun e pacientit.
Në rastin e leucemisë limfocitare kronike, lloji që kishte Olson, kanceri përfshinte qelizat B, qelizat antitrupa të sistemit imunitar. Qelizat T të pacientit mësohen të njohin qelizat B dhe t’i shkatërrojnë ato. Rezultati, nëse trajtimi do të kishte sukses, do të ishte shkatërrimi i çdo qelize B në trup. Pacientët do të mbeten pa qeliza B. Por edhe pa kancer. Ata do të kërkonin infuzione të rregullta të antitrupave në formën e infuzioneve të imunoglobulinës. Terapia ka ndihmuar shumë me kancerin e gjakut dhe ka rezultuar veçanërisht efektive në pacientët me leucemi akute dhe kancere të tjera të gjakut. Në të kundërt, ata si Olson me leucemi limfocitare kronike, e njohur gjithashtu si CLL, kanë parë më pak sukses. Midis atyre me atë kancer, rreth një e treta deri në një të pestën shkojnë përmirësohen me terapinë CAR T.
Ekspertët thanë se leucemia është zhdukur, por qelizat ende funksionojnë dhe nuk është shumë e sigurt nëse kanceri nuk kthehet më.
“Historikisht, nëse këto kancere nuk përsëriten në dy deri në pesë vjet, gjasat e rikthimit janë të ulëta,” tha Hagop M. Kantarjian, kryetar i departamentit të leucemisë në Qendrën e Kancerit MD Anderson të Universitetit të Teksasit.
Burimi: The New York Time/ Përshtati: Gazeta “Si”
Copyright © Gazeta “Si”
Të gjitha të drejtat e këtij materiali janë pronë ekskluzive dhe e patjetërsueshme e Gazetës “Si”, sipas Ligjit Nr.35/2016 “Për të drejtat e autorit dhe të drejtat e tjera të lidhura me to”. Ndalohet kategorikisht kopjimi, publikimi, shpërndarja, tjetërsimi etj, pa autorizimin e Gazetës “Si”, në të kundërt çdo shkelës do mbajë përgjegjësi sipas nenit 179 të Ligjit 35/2016.
.png)




Lini një Përgjigje